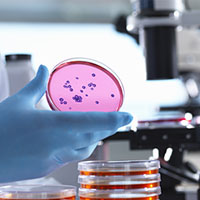
Micro_200.jpg Micro_200.jpg

Analysis for microbiological testing
Accurately identifying and documenting microorganisms within samples is one of the most critical steps in microbiological research and testing. Avantor® offers a comprehensive portfolio of rapid tests, standard analyses and other products so you can fully equip your lab and support your microbiology research and analysis processes.
Let Avantor® help you move science forward.
We can help you select the best microbiological testing products and systems for your research and analysis needs.
Testing products and supplies for a broad range of microorganism identification tasks.
Microbial identification
Avantor® offers nearly everything you need for the microbiological analysis of samples, from simple manual tools such as Petrifilm™ and test kits for rapid identification to microscopes and automatic colony counters.

Sequencing-based microbial identification and characterization
Nanopore sequencing is a powerful laboratory technique that determines the order of bases in a DNA or RNA molecule. Avantor® supports this advanced technique with affordable, real-time nanopore sequencing tools so you can identify and fully characterize microorganisms from culture or mixed metagenomic samples.

Rapid microbial tests
Faster testing without sacrificing quality results. Obtaining reliable, unambiguous data in the shortest time possible is critical for clinical diagnostics labs and QC operations. We offer different brands of monitoring and detection systems, combining instruments with specific swabs or kits as well as easy-to-use detection cards.